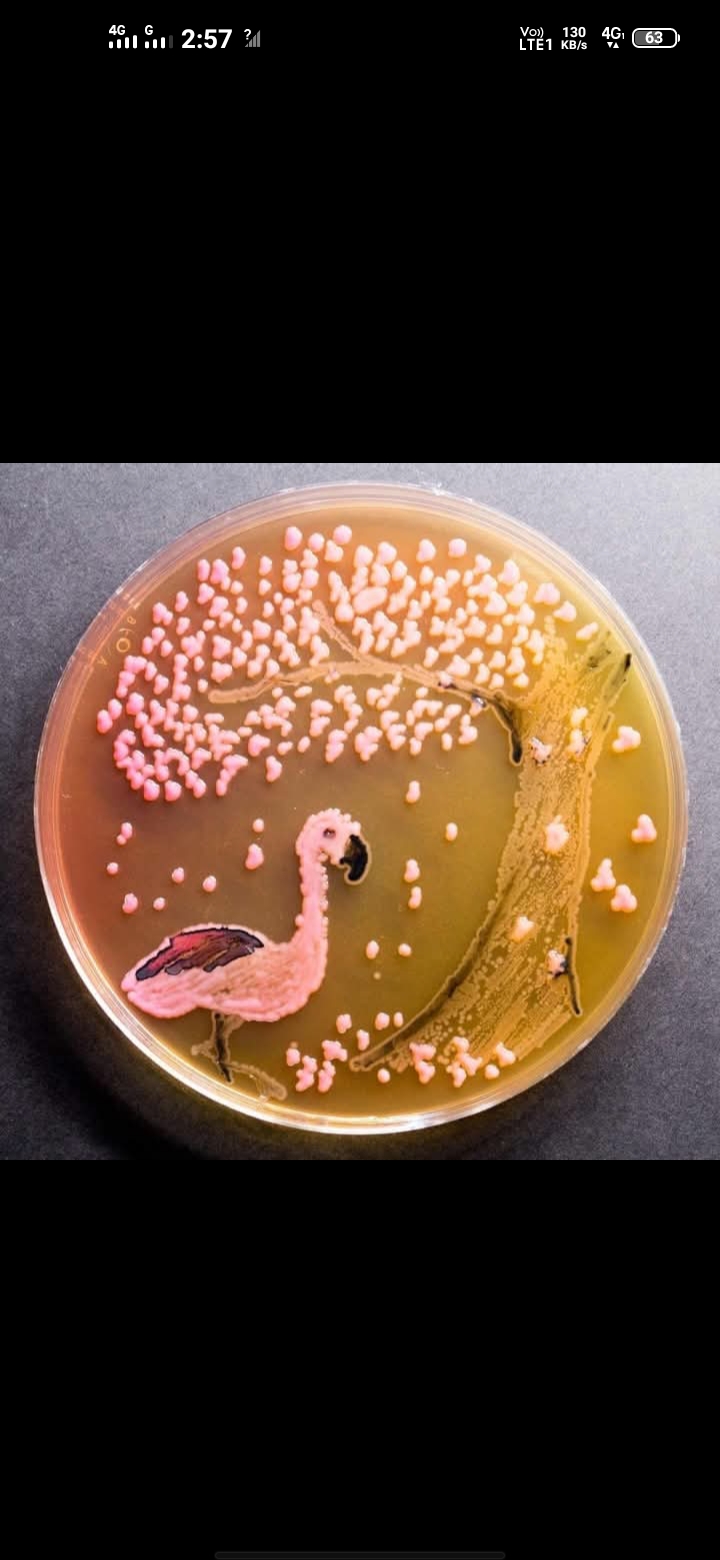

Contact Information
Availability
Available Days
MONDAY
Qasim
Cvas Jhang
MALEA -StudentPartner since 8 months ago
Academic Information
Current Studies
Applied Microbiology
Student ID
Hi y
Associated Resources (0)
No resources associated with this student yet.